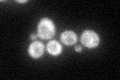
YMR080C
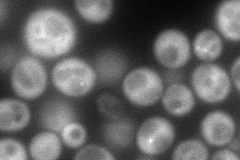
YMR080C
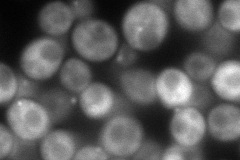
YMR080C
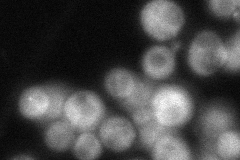
YMR080C
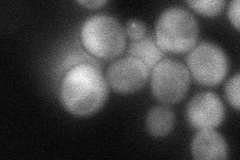
YMR080C
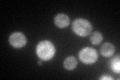
YMR080C
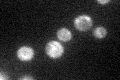
YMR080C

View description
ATP-dependent RNA helicase of the SFI superfamily involved in nonsense mediated mRNA decay; required for efficient translation termination at nonsense codons and targeting of NMD substrates to P-bodies; involved in telomere maintenance
Localization:
Intensity:
Fold change:
Significance:
-
C’ GFP library in SD
cytosol58.32 -
N' NOP1pr-GFP in SD
cytosol,punctate155.574 -
N' TEF2pr-mCherry in SD
punctate154.035 -
N' NATIVEpr-GFP in SD
ambiguous,cytosol52.0818 -
N' TEF2pr-VC and Cyto-VN in SD
cytosol,punctate68.3526 -
C’ GFP library in SD+DTT
cytosol57.680.98No -
C’ GFP library in SD+H2O2

cytosol61.61.05No -
C’ GFP library in Starvation Media
cytosol46.280.79No -
C’ GFP library on the background of Pup2-DaMP

N/A -
C’ GFP library on the background of CCT mutant

N/A0N/AYes
